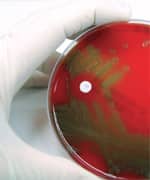
The Skin’s Structure

Life Extension Magazine®
As you age, your skin progressively loses natural lipids called ceramides.1-4 The result is visible aging that includes wrinkles, age spots, and rough, uneven skin.5-8
Ceramides are major skin components that help form the “glue” that holds surface cells together.9,10 Depletion of these molecules not only causes skin to wrinkle, but also makes it more susceptible to moisture loss, environmental allergens, skin diseases such as atopic dermatitis, and possibly cancer.5,11-13
For these reasons, ceramides have long been a key ingredient in expensive skin creams. The problem is that topical application may not penetrate deeply enough into the skin to effectively block wrinkle formation and skin aging.
Fortunately, plant-derived ceramides—or phytoceramides—have been developed that can be taken orally, likely stimulating the body to produce its own ceramides that are incorporated into the skin. These rejuvenating molecules are enriched in skin all over the body, not just where creams are applied.
Oral phytoceramides effectively work from the inside out to hydrate, smooth, and rejuvenate aging and wrinkled skin.14,15
Your Skin’s Natural Regeneration Molecules
As the years pass, ceramide production declines dramatically. Without substantial replenishment of ceramides, the mortar that holds the skin-cell bricks together deteriorates, and the skin moisture barrier becomes greatly compromised.9,14,16
The result is a thinning of your skin—with noticeable wrinkles, dryness, roughness, and even infection.14,17-19
Although ceramides are present in many of the foods we eat, including rice and wheat, they do not naturally occur in sufficient quantities to optimally rejuvenate aging skin.14 This means that slowing and reversing skin aging requires effective supplementation.
The Phytoceramide Breakthrough
To help prevent skin infections, skin dryness, and wrinkling, researchers have investigated the effectiveness of topically applying ceramides to the skin surface. What they discovered is that adding lipids such as ceramides directly to the skin can improve the moisture barrier function—but only modestly.14,20,21 The problem is that a topical ceramide application is not the body’s natural route for infusing the skin’s outer layer with ceramide molecules—that occurs from the inside out.
That’s why creams and lotions, applied to the outer surface of the skin, simply can’t match the steady supply of ceramides that naturally comes from healthy, youthful skin.
To solve this problem, researchers turned their attention to oral ceramides. Initially, research focused on identifying potentially useful oral ceramides only from animal sources.14 Then scientists switched to using a number of different ceramides available in grains such as rice, corn, and wheat.14,21 These plant-based ceramides are called phytoceramides.
In an important breakthrough, scientists developed a proprietary wheat-derived phytoceramide extract. Taken orally, it aids in restoring the barrier function.14
This innovation was achieved by using natural, nongenetically modified wheat as the raw material and producing an extract containing only purified oils.14 This extract is so purified it is classified as gluten-free by current government standards. A number of studies now validate the effectiveness of this novel phytoceramide.14,15,22
In a laboratory cell study, this wheat-derived extract was shown to hydrate human skin and restore its youthful structure after the skin cells’ protective barrier function had been disrupted.22
This study also found that wheat phytoceramides reduced levels of free radicals in the skin and inhibited elastase enzymes, which would ordinarily destroy elastin and contribute to loss of skin flexibility and increased wrinkling.23
Ceramides have also been shown to inhibit melanogenesis, the process by which the skin produces the hyperpigmentation behind age spots and other discolorations of the skin. This suggests that by replacing ceramides from the inside out, oral wheat-derived phytoceramides may inhibit or reverse the uneven pigmentation of skin aging.7,8,24
Scientists realized that if clinical trials validated these effects in humans, it would at last be possible to rejuvenate aging skin—simply by swallowing a capsule.
What You Need To Know
![]() |
Rejuvenate Skin From The Inside Out
- Natural skin-based lipid molecules—called ceramides—have shown critical capacity to preserve youthful-looking skin and strong defenses against certain skin diseases and infections.
- They critically maintain the water-retaining properties of the skin by blocking water loss from aging or physical trauma.
- As we age, the skin content of ceramides substantially decreases, and topically applied ceramide-containing creams have shown limited effectiveness.
- Natural phytoceramides can be taken orally, working from the inside out to improve the skin barrier function.
- Placebo-controlled, clinical studies show that oral wheat-derived phytoceramides boost skin hydration, smoothness, suppleness, and other measures of youthful skin. Ceramides also defend against skin-based infections and diseases.
Phytoceramides’ Effectiveness Validated In Clinical Trials
To demonstrate wheat-derived phytoceramides’ effectiveness, investigators conducted experiments of the scientifically most rigorous type: double-blind, placebo-controlled, clinical studies.
In the first study, women with dry to very dry skin were given 200 mg daily of either a placebo or a powdered phytoceramide extract for three months. Skin hydration was then evaluated using three distinct methods: a special testing machine, a dermatologist’s examination, and the subjects’ own subjective scores.15
The women taking the phytoceramide extract experienced significant improvement in skin hydration as assessed by all three of these testing methods. Additionally, in the ceramide group, participants experienced significantly reduced dry patches, roughness, and itching.15 These changes were not seen in the placebo arm of the study. This placebo-controlled human data provided scientists with a clear indication that the phytoceramides had made their way through the bloodstream to the skin cells, where they provided a powerful rehydrating and rejuvenating effect.15
To confirm these remarkable results, another clinical trial evaluated the wheat-derived phytoceramide extract in its oil form.14 For the study, women with dry to very dry skin took 350 mg daily of the wheat ceramide oil, or a placebo, in a double-blind trial. Results were assessed after just three months of supplementation.14
First, researchers objectively measured skin hydration using a special technique known as corneometry. The supplement, but not the placebo, was shown to significantly increase skin hydration of the arms, legs, and the body overall. On the arms, skin hydration increased by more than 35%, compared to less than 1% in the placebo group.14
Second, researchers asked participants to rate their own perceptions of the effects of the supplement or placebo treatments. At all points of measurement in the study, the wheat phytoceramide oil extract provided greater improvement in all factors—facial skin hydration, leg skin hydration, suppleness, roughness, uniformity of complexion, itchiness, and overall state of the skin—without any significant adverse effects and with a superior level of acceptability.14
These controlled clinical trials delivered clear confirmation that orally taken wheat-derived phytoceramides substantially boost skin hydration, smoothness, suppleness, and other levels—reflecting reversal of age-related skin wrinkling, drying, and decline.14
What Are Ceramides?
![]() |
Ceramides are components of specialized lipid molecules called sphingolipids, an essential element of human skin.41
The presence of ceramides as a category within sphingolipids was first discovered in the human brain in 1884.42 The ceramides that are found in both plants and the human body are now known to be structurally similar.19
All four layers of the epidermis contain ceramides, and they play a critical role in skin health by creating a barrier that reduces infection and helps to retain the skin’s moisture and smoothness.19
Over a period of four weeks, new cells created at the deepest epidermal layer migrate upwards to form the top layer of the skin (the stratum corneum) where extracellular matrix lipids inhibit loss of water.43 By the time skin cells reach the skin’s surface, they become cornified or horn-like, transforming into protein-rich bricks tightly bound together by a layer of mortar composed of various lipids, up to 50% of which are ceramides.44
The primary function of the epidermis is to generate a relatively impermeable layer to protect the skin from dehydration and environmental stress.44 Ceramides play a critical role in this barrier function and in the retention of water by the stratum corneum.44
The aging process reduces the content of ceramides in the epidermal skin layers. This contributes to dry skin and dermatitis, and is a major cause of skin wrinkling.1-6,9-12
Research has shown that optimal amounts of ceramides, in relation to other lipids, in the top layer of the skin are required to maintain youthful and healthy skin.12,44
Wrinkled, dry, irritated, and sensitive skin often lacks ceramides. Topical application of ceramides has shown limited benefit. However, orally taken wheat-derived phytoceramides—both in powdered and oil form—have been clinically demonstrated to hydrate skin and promote more youthful appearance and smoothness.14,15
Why You Need To Replace Age-Diminished Ceramides
Because ceramides are bioactive lipids,25 they are involved in much more than the appearance of the skin—and their age-related decline represents more than a mere cosmetic problem. Full functionality of the skin—which requires adequate ceramides and intact barrier function—helps regulate body temperature, synthesize optimum amounts of vitamin D, and provide critical sensory input from the environment.26-28
By contrast, falling ceramide levels expose one to health risks due to greater susceptibility to contact dermatitis from environmental chemicals, infectious microorganisms, and altered permeability to topically administered drugs.4,18,29 As shown in research, the outer layer ( stratum corneum) in aging human skin has decreased moisture content17,30,31 with greater susceptibility to inflammation32 and infection.19
Scientists have also determined that as humans age, their skin’s diminished lipid content—mostly a decreased level of ceramides4—results in reduced structural integrity.10,17,33 This loss of structural integrity exposes the skin to a greater threat from environmental assaults, such as low humidity, solvents, and detergents, and a much lower capacity to recover from them.11
Research suggests that the decline in ceramide content in mature skin4 may stem from a decline in the enzyme activity that normally promotes the delivery of ceramides in a usable form to the skin.34
To inhibit the loss of skin ceramides—and the wrinkling, moisture loss, and multiple health risks that occur as a result—it is essential to boost ceramide levels not just on the surface where lotions sit, but deep inside the skin cells beneath the stratum corneum.
In addition, maintaining youthful levels of ceramides in all layers of the skin promotes more than better appearance and feel—it powerfully blocks skin infections18 and other skin diseases.4,11
The Skin’s Structure
![]() |
The outer layer of your skin (epidermis) plays a key role in maintaining homeostasis,45 the internal process that automatically modulates internal conditions to keep them constant and stable throughout your body. The skin surface, or stratum corneum, serves as a barrier between the external environment and the internal body. This barrier prevents water loss due to evaporation and inhibits foreign insults.9,45
Scientists often describe the structure of the stratum corneum as “bricks and mortar.”45 About 90% of the stratum corneum surface is made up of cells called keratinocytes.46 These are the “bricks” of the skin barrier.
Between those cells are intercellular lipids that are made up of ceramides, free fatty acids, and cholesterol, all of which constitute the “mortar” that holds the “bricks” of your stratum corneum together.9 Ceramides comprise up to 50% of this vital intercellular material.44
This brick-and-mortar structure effectively prevents transepidermal water loss,9 unless impaired by damage to the stratum corneum, a tragic effect of skin aging.
Protection Against Skin Infections And Diseases
Lipids at the skin’s surface, including ceramides, comprise a major part of an antimicrobial barrier, the first line of defense against infection. Age-related deterioration of this barrier raises the risk of numerous health conditions.11
For example, atopic dermatitis is characterized by reduced ceramide concentrations in the stratum corneum.12,35 Scientists suggest a correlation between this reduction and higher concentrations and colonization of Staphylococcus aureus in atopic dermatitis.12,36,37 This can be especially concerning because when skin barrier function is disrupted—as it is with diminished ceramide content—S. aureus has an increased potential for causing infections.38 In addition, disruption of skin barrier function is a risk factor for infection with various microorganisms including Streptococcus pyogenes.39
A scientific investigation into the pathogenesis of allergic contact dermatitis and other inflammatory skin conditions found that repairing the breakdown in the ceramide barrier, while continuing topical medications, could greatly alleviate atopic dermatitis.40 This is especially significant, because the topical corticosteroids and other immunosuppressive agents of mainstream therapy involve toxicity risks.
Summary
Ceramides are natural skin-based lipid molecules that have shown critical importance in preserving skin’s youthful appearance and texture, as well as providing strong defenses against skin diseases.
Their essential role is in the maintenance of water-retaining properties of the skin, protecting against water loss of both physical trauma and aging.
With age, the presence of ceramides in the skin decreases. However, topical creams that contain ceramides have shown only modest effectiveness.
When taken orally, phytoceramides work from the inside out to improve the skin barrier function.
Rigorous clinical studies show that oral wheat-derived phytoceramides increase skin hydration, smoothness, suppleness, and other measures of youthful skin. Ceramides may also protect against skin-based infections and diseases.
If you have any questions on the scientific content of this article, please call a Life Extension® Health Advisor at 1-866-864-3027.
References
- Rogers J, Harding C, Mayo A, Banks J, Rawlings A. Stratum corneum lipids: the effect of ageing and the seasons. Arch Dermatol Res. 1996 Nov;288(12):765-70.
- Denda M, Koyama J, Hori J, et al. Age- and sex-dependent change in stratum corneum sphingolipids. Arch Dermatol Res. 1993;285(7):415-7.
- Boireau-Adamezyk E, Baillet-Guffroy A, Stamatas GN. Age-dependent changes in stratum corneum barrier function. Skin Res Technol. 2014 Feb 12.
- Imokawa G, Abe A, Jin K, Higaki Y, Kawashima M, Hidano A. Decreased level of ceramides in stratum corneum of atopic dermatitis: an etiologic factor in atopic dry skin? J Invest Dermatol. 1991 Apr;96(4):523-6.
- Yarosh DB, Both D, Brown D. Liposomal ursolic acid (Merotaine) increases ceramides and collagen in human skin. Horm Res. 2000;54:318-21.
- Motta S, Monti M, Sesana S, Caputo R, Carelli S, Ghidoni R. Ceramide composition of the psoriatic scale. Biochim Biophys Acta. 1993 Sep 8;1182(2):147-51.
- Kim DS, Kim SY, Chung JH, Kim KH, Eun HC, Park KC. Delayed ERK activation by ceramide reduces melanin synthesis in human melanocytes. Cell Signal. 2002 Sep;14(9):779-85.
- Jeong HS, Choi HR, Yun HY, et al. Ceramide PC102 inhibits melanin synthesis via proteasomal degradation of microphthalmia-associated transcription factor and tyrosinase. Mol Cell Biochem. 2013 Mar;375(1-2):81-7.
- Coderch L, López O, de la Maza A, Parra JL. Ceramides and skin function. Am J Clin Dermatol. 2003;4(2):107-29.
- Rabionet M , Gorgas K, Sandhoff R. Ceramide synthesis in the epidermis. Biochim Biophys Acta. 2014 Mar;1841(3):422-34.
- Proksch E, Brandner JM, Jensen JM. The skin: an indispensable barrier. Exp Dermatol. 2008 Dec;17(12):1063-72.
- Choi MJ, Maibach HI. Role of ceramides in barrier function of healthy and diseased skin. Am J Clin Dermatol. 2005;6(4):215-23.
- Guenther GG, Edinger AL. A new take on ceramide: starving cells by cutting off the nutrient supply. Cell Cycle. 2009 Apr 15;8(8):1122-6.
- Guillou S, Ghabri S, Jannot C, Gaillard E, Lamour I, Boisnic S. The moisturizing effect of a wheat extract food supplement on women’s skin: a randomized, double-blind placebo-controlled trial. Int J Cosmet Sci. 2011 Apr;33(2):138-43.
- Boisnic S. Clinical evaluation of a hydrating food supplement: double blind randomized study versus placebo. HITEX. 2005.
- Takagi S, Tojo H, Tomita S, et al. Alteration of the 4-sphingenine scaffolds of ceramides in keratinocyte-specific Arnt-deficient mice affects skin barrier function. J Clin Invest. 2003 Nov;112(9):1372-82.
- Leveque JL, Corcuff P, de Rigal J, Agache P. In vivo studies of the evolution of physical properties of the human skin with age. Int J Dermatol. 1984 Jun;23(5):322-9.
- Jennemann R, Rabionet M, Gorgas K, et al. Loss of ceramide synthase 3 causes lethal skin barrier disruption. Hum Mol Genet. 2012 Feb 1;21(3):586-608.
- Available at: http://www.fda.gov/ohrms/dockets/dockets/95s0316/95s-0316-rpt0275-04-udell-vol211.pdf. Accessed August 25, 2014.
- Yilmaz E, Borchert HH. Effect of lipid-containing, positively charged nanoemulsions on skin hydration, elasticity and erythema—an in vivo study. Int J Pharm. 2006 Jan 13;307(2):232-8.
- Asai S, Miyachi H. Evaluation of skin-moisturizing effects of oral or percutaneous use of plant ceramides. Rinsho Byori. 2007 Mar;55(3):209-15.
- Boisnic S, Beranger JY, Branchet MC. Cutaneous hydration evaluation after a vegetal ceramide-based cream application on normal human skin tissue model maintained alive, submitted to a dehydration model. HITEX;2003.
- Boisnic S, Beranger JY, Branchet MC. Anti-elastase and anti-radicalar effect of ceramides. Product Research Report. HITEX;2005.
- Kim DS, Kim SY, Moon SJ, Chung JH, Kim KH, Cho KH, et al. Ceramide inhibits cell proliferation through Akt/PKB inactivation and decreases melanin synthesis in Mel-Ab cells. Pigment Cell Res. 2001 Apr;14(2):110-5.
- Bielawski J, Pierce JS, Snider J, Rembiesa B, Szulc ZM, Bielawska A. Comprehensive quantitative analysis of bioactive sphingolipids by high-performance liquid chromatography-tandem mass spectrometry. Methods Mol Biol. 2009;579:443-67.
- Charkoudian N. Skin blood flow in adult human thermoregulation: how it works, when it does not, and why. Mayo Clin Proc. 2003 May;78(5):603-12.
- Webb AR . Who, what, where and when-influences on cutaneous vitamin D synthesis. Prog Biophys Mol Biol. 2006 Sep;92(1):17-25.
- Yu YD, Zhang YZ, Bi WD, Wu T. Functional sensory function recovery of random-pattern abdominal skin flap in the repair of fingertip skin defects. Exp Ther Med . 2013 Mar;5(3):830-4.
- Perry AD, Trafeli JP. Hand dermatitis: review of etiology, diagnosis, and treatment. J Am Board Fam Med 2009;22:325-30.
- Man MQ, Xin SJ, Song SP, Cho SY, Zhang XJ, Tu CX, et al. Variation of skin surface pH, sebum content and stratum corneum hydration with age and gender in a large Chinese population. Skin Pharmacol Physiol. 2009;22(4):190-9.
- Potts RO, Buras EM, Chrisman DA Jr. Changes with age in the moisture content of human skin. J Invest Dermatol. 1984 Jan;82(1):97-100.
- Available at: http://www.ncbi.nlm.nih.gov/pubmedhealth/pmh0003734. Accessed August 25, 2014.
- Del Rosso JQ, Levin J. The clinical relevance of maintaining the functional integrity of the stratum corneum in both healthy and disease-affected skin. J Clin Aesthet Dermatol. 2011 Sep;4(9):22-42.
- Yamamura T, Tezuka T. Change in sphingomyelinase activity in human epidermis during aging. J Dermatol Sci. 1990 Mar;1(2):79-83.
- Imokawa G. Lipid abnormalities in atopic dermatitis. J Am Acad Dermatol. 2001 Jul;45(1 Suppl):S29-32.
- Abeck D, Mempel M. Staphylococcus aureus colonization in atopic dermatitis and its therapeutic implications. Br J Dermatol. 1998 Dec;139 Suppl 53:13-6.
- Arikawa J, Ishibashi M, Kawashima M, Takagi Y, Ichikawa Y, Imokawa G. Decreased levels of sphingosine, a natural antimicrobial agent, may be associated with vulnerability of the stratum corneum from patients with atopic dermatitis to colonization by Staphylococcus aureus. J Invest Dermatol. 2002 Aug;119(2):433-9.
- Fritz SA, Hogan PG, Hayek G, et al. Staphylococcus aureus colonization in children with community-associated Staphylococcus aureus skin infections and their household contacts. Arch Pediatr Adolesc Med. 2012 Jun 1;166(6):551-7.
- Lamagni TL, Neal S, Keshishian C, et al. Severe Streptococcus pyogenes infections, United Kingdom, 2003-2004. Emerg Infect Dis. 2008 Feb;14(2):202-9.
- Chamlin SL, Kao J, Frieden IJ, et al. Ceramide-dominant barrier repair lipids alleviate childhood atopic dermatitis: changes in barrier function provide a sensitive indicator of disease activity. J Am Acad Dermatol. 2002 Aug;47(2):198-208.
- Novotny J, Hrabalek A, Vavrova K. Synthesis and structure-activity relationships of skin ceramides. Curr Med Chem. 2010;17(21):2301-24.
- Available at: http://www.oryza.co.jp/html/english/pdf/ceramide_clinical.pdf. Accessed August 25, 2014
- Goldstein AM, Abramovits W. Ceramides and the stratum corneum: structure, function, and new methods to promote repair. Int J Dermatol. 2003 Apr;42(4):256-9.
- Feingold KR, Elias PM. Role of lipids in the formation and maintenance of the cutaneous permeability barrier. Biochim Biophys Acta. 2014 Mar;1841(3):280-94.
- Harding CR. The stratum corneum: structure and function in health and disease. Dermatol Ther. 2004;17(Suppl):6-15.
- Wong DJ, Chang H. Stem Book; 2009: Cambridge, MA. HY Skin tissue engineering.